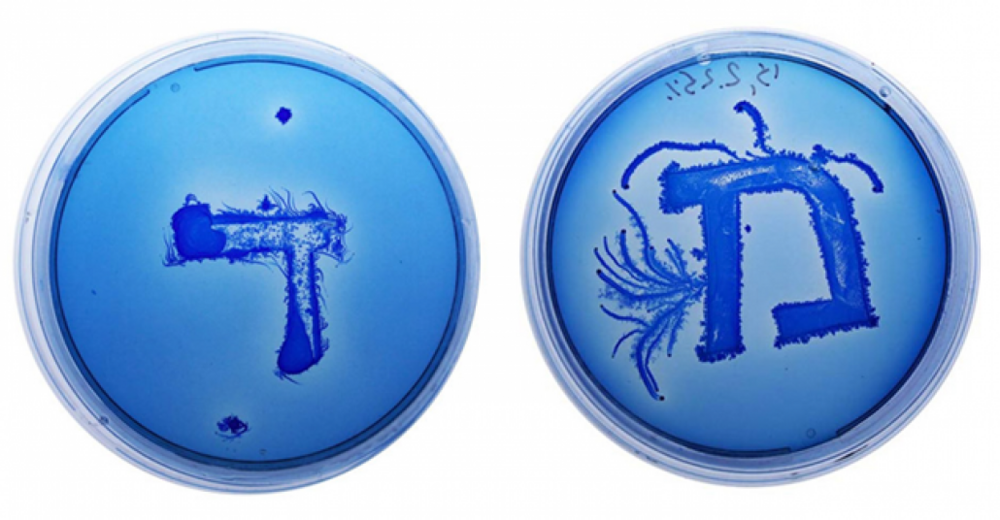

Geride bıraktığımız hafta içerisinde Apple’ın iOS 9’u yayınlaması ve iPhone 6S hakkındaki yorumların yerleşmesi dikkat çekti. Yeni teknoloji ve ürün sunumu dönemini Hey Siri ile tamamlayan Apple’ın ardından Microsoft ve Google da gelecek konferanslarının tarihini açıkladı.
Sinema dünyasındaysa bu hafta Quentin Tarantino’nun Pulp Fiction için baş rollere belirlediği oyuncu listesi, Pacific Rim 2’nin iptal edilmesi ve Akira’nın Christopher Nolan yönetmenliğinde üçleme olacağı haberleri gündemi meşgul etti.
Snapchat, Lenses özelliğiyle kullanıcılarına animasyonlaştırılmış selfieler sunarken mobil platformun en popüler reklam engelleme uygulaması Peace, AppStore’dan kaldırıldı. Twitter e-ticaret ve Başkanlık seçimlerinde doğrudan bağış yapma ortalıkları yaparken, ev yapımı saatiyle okula giden Ahmed’in bomba şüphesiyle tutuklanması ABD’de haftanın en önemli gelişmesi oldu.
Başkasının yumurtasını çalan gay penguenler, Doritos’un gökkuşağı renkli cipsleri ve Minyon’a dönüşen Yeşilçam karakterleriyle geçtiğimiz hafta olan biten tüm gelişmeleri takip edebileceğiniz Bigumigu Pazar Gazetesine hoş geldiniz, iyi okumalar!
Haftanın Müziği:
2001’den bu yana müzik kariyerine devam eden Kanadalı I Am Robot and Proud, 10. stüdyo albümü Light and Waves’i yayınladı. Aynı zamanda oyun tasarımcısı olan sanatçı, IDM ve Indietronica altyapılarında hafif ve neşeli müzikler üretiyor. IDM’in sunduğu katmanlı müzik yapısıyla birlikte I Am Robot and Proud, hikayeleştirilebilen parçalarla farklı dünyalarda küçük kaçamaklar vadediyor.
Nashville çıkışlı indie, pop rock sanatçısı Meg Myers, ikinci stüdyo albümü olan Sorry’yi yayınladı. Albüm temelde Amerikan Country tonlarının kadın vokal ile buluşması ve modern seslerin yakalanması üzerine kurulu. Kadın vokaller arasında yer bir ses olan Meg Myers, farklı bir ton dinlemek isteyenler için şık bir alternatif.
spotify%3Aalbum%3A3qcr3UAjcc7ylfNEqi49k4
Dizi ve Sinema:
- Quentin Tarantino’nun sinema tarihine kattığı kült yapımlardan Pulp Fiction için yönetmenin baş roller için öncelikli belirlediği oyuncuların listesi bu hafta internete sızdı. Eğer o gün düşünülen oyuncular bu rolleri kabul etseydi çok farklı bir film izleyecektik.
Görsel; Consequence of Sound
- Dev robotları ve canavarlarıyla yaş gözetmeksizin izleyenleri çocuksu heyecandan tatminin doruklarına çıkaran Pacific Rim’in 2017’de vizyona girecek devam filminin iptal edildiği açıklandı. Fakat Guillermo del Toro, Twitter’dan yaptığı açıklamayla daha fazla iptal edilen devam filminin olmaması için şeytanın bacağını kırarak bu filmi gerçekleştirmeye çalışacağını belirtti.
- Cyberpunk yapımlar arasında 1988 yapımı Akira’nın yeri bu türü sevenler için ayrı anlamlar taşıyor. Warner Bros’a yakın kaynakların söylemlerine göre Akira, beyazperdeye tekrar uyarlanacak ve üçleme olacak. Filmlerin yönetmeni ise Christopher Nolan olacak.
- Venedik Film Festivali’nde Jüri Özel Ödülü kazanarak ismini duyan Sivas filmi, bu yıl En İyi Yabancı Film dalında Türkiye adına aday oldu.
- Disney’in klasikleşmiş animasyonlarından The Jungle Book beyazperdede boy göstermeye hazırlanıyor. Filmin ilk fragmanı da bu hafta içinde yayınlandı.
Dijital Yaşam:
- Tokyo Flash isimli Japon saat üreticisi, yeni serisinde sandal ağacını ve LED teknolojisini kullanarak hem doğal görünümlü hem de akıllı saat özelliklerine sahip özel seri hazırladı.

- Swatch’un akıllı saat dünyasına adım attığı modeli Touch Zero One, Türkiye’de satışa çıktı. 6 farklı modeli olan ürün, sportif aktiviteler üzerine odaklanıyor.
- StudioBananThings tarafından geliştirilen Batband isimli kulaklık, kemik üzerinden sinyal iletme teknolojisini kullanarak kulakla değil kafatasıyla müzik dinlemeyi sağlıyor. Aynı zamanda kulaklarla da iletişim kurmaya imkan tanıyan Batband bu yönüyle kullanıcılarına bambaşka bir deneyim vaadediyor.
https://www.youtube.com/watch?v=ozTiogpOol8
- Hem mobil hem de masaüstü platformlarda, tarayıcı reklamlarını engelleyen eklentiler ve reklam göstermeyen tarayıcılar, kullanıcıların özellikle tercih ettiği popüler yazılımlar haline geldi. Bu kanallar üzerinden pazarlama faaliyeti yürüten markalar farklı teknikler üretirken son dönemde birçok internet sitesi, reklam engelleme eklentilerini fark ettiğinde bir uyarı eşliğinde bunun kapatılmasını talep ediyor. İnternet sitelerinin bu akımının, eklenti kullanım trendi kadar büyük bir etki yaratması bekleniyor.
- Mobilde ise Adblock Plus’ın bir uygulama geliştirdiğinden bahsetmiştik. Instapaper’ın geliştiricisinin markete sunduğu ve US App Store’da bir numaraya kadar çıkan reklam engellemeli tarayıcı Peace bu hafta App Store’dan silindi. Peace’in geliştiricisi reklam engelleme konusunda bu kadar keskin çözümlerin bazı tarafları incitebileceğine karar verdiğini ve bunun bir parçası olmak istemediğini söylüyor.
- Tesla Motors’un dünyaya yüksek performanslı elektrikli araç kullanımının mümkün olduğunu ispatlayıp ABD’nin büyük bir kısmına şarj istasyonu kurup Avrupa’ya açılmasından sonra Rusya hükümeti de tüm benzin istasyonlarını elektrikli araçları destekleyecek şekilde güncelliyor. Kasım 2016’ya kadar ülke çapında tüm akaryakıt istasyonları elektrikli araç da şarj edebilecek.
- Sony’nin sanal gerçeklik çalışması Project Morpheus resmi adı Tokyo Game Show’da yapılan oturumla birlikte duyuruldu, cihazın adı artık PlayStation VR.
- Uber ve Lyft, 15 Eylül’de, aynı gün içerisinde Las Vegas’ta hizmet vermeye başladı. Bu gelişme iki marka arasındaki rekabete ışık tutar nitelikte yorumlandı.
- HTC ve Spotify bir araya gelerek özçekiminize (selfie) özel çalma listesi hazırlayan bir algoritma geliştirdi. Yüz tanıma teknolojisini kullanarak ruh halini analiz eden sistem o ana uygun parçalarla kişiye özel seçimler yapıyor.
- Rivayetlere göre Samsung, katlanabilen ve bükülebilen bir ekran üzerinde çalışıyor ve ilk ürününü Ocak ayında piyasaya sürecek.
Google:
- Özel temalara ve markalara küçük sürprizler yapmayı seven Google, Super Mario’nun 30. yaşı için arama motoruna minik bir detay sakladı. Super Mario Bros yazarak aratıldığında sağ tarafta çıkan soru işaretinden tıpkı oyundaki gibi yüzlerce puan kazanabiliyoruz.
- 2. Dünya Savaşı’ndan bu yanan dünyanın gördüğü en büyük göçmen ve mülteci krizini yaşıyoruz. Google düzenlediği bağış kampanyasında yapılan bağış miktarına eş değerde miktarı da kendi fonluyor. 10 milyon doları hedefleyen Google, 5 milyon dolar bağışlandığında 5 milyonu da kendi ekleyecek.
- Google’ın yeni nesil Nexus telefonunu tanıtacağı konferansın tarihi 29 Eylül olarak açıklandı.
- Android’in mobil ödeme uygulaması Android Pay, Google Play’deki yerini aldı ve çok yakında ABD’de hizmete girecek.
Microsoft:
- Microsoft, yeni yüzü ve işletim sistemi Windows 10 ile geliştirdiği akıllı telefon, tablet gibi cihazları 6 Ekim’de düzenleyeceği bir konferans ile duyuracağını açıkladı.
Apple:
- Hey Siri etkinliğiyle iPhone 6S ve 6S Plus, iPad Pro gibi yeni ürünlerini tanıtanApple, bu hafta başı Jimmy Kimmel’ın radarına takılmıştı. 2007’de yayınlanan orijinal iPhone’u, iPhone 6S olarak tanıtarak sokak röportajına çıkan Kimmel, teknolojiye dair dile getiremediğimiz gerçekleri ortaya koydu.
- Hey Siri konferansının kayda değer ürünlerinden WatchOS 2’nin çıkış tarihi, tam olarak tespit edilemeyen bir yazılım hatası (bug) nedeniyle ertelendi.
- iPhone 6S Plus’ın üretim aşamasında yaşanan bir sorun da kullanıcıyla buluşma tarihini erteldi. Çin’deki ekran üreticilerinden birisinin yaşadığı parlaklık ve arka fon ışığı problemi bu ertelemenin temel sebebi.
- Multi Touch’tan sonraki arayüz teknolojisi 3D Touch hakkındaysa uygulamayı açmadan erişim sağlamasıyla diğer arayüz tasarımlarında bulunan üç yatay çizgilik ayarlar butonu hamburger menüyü tarihe karıştıracağı yönünde yorumlar yapılıyor.
- Yeni Apple TV bir multimedya ve oyun platformuna dönüşürken sadece oyun kumandası ile oynanan oyunların TV App Store’da yer almayacağını açıkladı.
- Apple tarafından yayınlanan ve her iPhone’un kullanılmayn uygulamalar klasöründe saklanan ön-yüklemeli ugulamalar, gelecek dönemde telefondan silinebilecek hale gelebilir.
Sosyal Medya:
- Adjustisimli mobil veri ve etkileşim analiz şirketi yayınladığı araştırmayla birlikte Instagram’ın mobil reklamlar üzerinde uygulama indirme oranında en etkili platform olduğunu açıkladı.
- Yakın bir zamanda canlı yayın desteği vereceğinin sinyallerini veren Facebook, ilk canlı yayınını Salı günü yaptı. Yayında Mark Zuckerberg ofis içinde gezerek hem gelecek projelerinden hem de ofisin anlık durumundan bahsetti.
(function(d, s, id) { var js, fjs = d.getElementsByTagName(s)[0]; if (d.getElementById(id)) return; js = d.createElement(s); js.id = id; js.src = “//connect.facebook.net/en_GB/sdk.js#xfbml=1&version=v2.3”; fjs.parentNode.insertBefore(js, fjs);}(document, ‘script’, ‘facebook-jssdk’));
- Zuckerberg, düzenlediği bir soru cevap oturumu sırasında “dislike” (beğenmeme) butonunun çok yakında aktif olacağını duyurdu. Sadece beğenmeme veya insanların moralini bozmak tuşu yerine empati kazanan bir özellik olacağını belirtti.
- Snapchat, uzun zamandır yaptığı en büyük güncellemeyi yayınladı ve Lenses isimli yeni özelliğini kullanıcılara sundu. Animasyon haline gelmiş selfie’ler sunan özellik yüz algılama temeline dayalı. Kullanıcıların ağzından gökkuşakları çıkarıyor, bir anda bilimkurgu filminden fırlamış pozlar vermemizi sağlıyor.
- Snapchat üzerinde bir kez izlenebilen içerikler, yapılan güncellenemeyle birlikte 1 dolar karşılında yeniden izlenebilir hale geldi. Eğer ABD’de yaşıyorsanız 1 Dolar karşılığında 3 snap yeniden izleyebiliyorsunuz..
- Stripe ve Twitter işbirliği yaparak yeni geliştirilen Relay isimli API’larını tanıttı. Relay sayesinde Twitter bir e-ticaret mecrasına dönüşebilecek ve alıcı ile satıcı çok daha hızlı bir şekilde bir araya gelebilecek.
- Twitter’ın bir başka ortaklığı da Square ile oldu. Seçim dönemine giren ABD’de adaylara Twitter üzerinden Square ile bağış yapmak mümkün.
- USA Today’in haberine göre Twitter, kullanıcılarının özel mesajlarını okuyup algoritmik tarama yaptığı için kullanıcıların gizliliğine aykırı hareket ettiği gerekçesiyle davalık oldu.
Uluslararası Gündem:
- Tatile çıktığı sırada Spotify üzerinden tatil temalı iki çalma listesi yayınlayan Obama, bu kez de rahatlama ve boş zamanı miskinlikle geçirmeyi çağrıştıran “Netflix and chill” çalma listesi yayınladı.
- Beyaz Saray, üniversite seçimi konusunda kararsızlık yaşayan gençler için kolej seviye bilgisini ve genel sıralamalarını içeren College Scorecard internet sitesini erişime açtı. Böylece karar aşamasındaki öğrenciler bölümleri ve okulları birçok farklı metrik üzerinden karşılaştırarak seçim yapabilecek.
- Amerika Birleşik Devletlerinin bu hafta gündemine oturan gelişme Teksas eyaletinde yaşayan Ahmed Mohamed ve kendi yaptığı saati alıp okula gidince ev yapımı bomba yaptığı gerekçesiyle tutuklanmasıydı.
- Kısa süre içerisinde serbest bırakılan Ahmed, yaşadıkları ve gördüğü tepkilerle Obama’nın bile gündemine girdi. “Senin gibi yaratıcı ve bilime meraklı gençlere ihtiyacımız var” şeklinde bir tweet atan Obama, Ahmed’i Beyaz Saray’a davet etti.
- Ahmed’in yaşadıkları sosyal medyada da büyük yankı uyandırdı. #IStandWithAhmed etiketiyle insanlar hislerini paylaştı.
- Microsoft da Ahmed’e karşı duyarlılığını göstererek ona küçük sürprizler yapan tepkisiz kalmayan markalar arasında yer aldı.
Görsel; Facebook
- Avrupa Adalet Divanı tarafından bu hafta alınan bir karar ile işe giderken harcanan süre de çalışılmış sayılacak ve ücret ödenecek.
- Donald Trump, başkanlığın yanı sıra önümüzdeki seçimlerde hakkında en çok içerik üretilecek ve ikonik bir karaktere dönüşecek ismi olmaya da aday. Tarihin derinliklerinden yakalanan bir detay da yüzleri güldüren nitelikte. Rage Against the Machine grubunun 1999 yılında Sleep Now in the Fire parçası için yayınladığı müzik videosunun 1. dakikasında Wall Street’te “Trump for President” tabelası tutan bir erkek figür görünüyor.
- AWOL ve yönetmen Vincent Rommelaere bir araya gelerek Burning Man festivalinin unutulmayacak anlarını birleştirip kısa film haline getirdi. Yapılan sanat yerleştirmeleri, araç modellemeleri, kum ve sıcak eşliğinde festivalin katılımcılarını bambaşka dünyalara nasıl taşıdığı sergileniyor.
Drone:
- İngiltere’de bir futbol stadyumu üzerinde uçan drone’un pilotuna, uçuş yasalarını ihlal ettiği gerekçesiyle ceza kesildi. Bu durum İngiltere için bir ilk oldu.
- ABD’yi ziyaret edecek olan Papa Francis’in çevresinde drone uçurmak yasaklandı.
- Burning Man’de ise gökyüzünden görüntü alan bir drone dans eden kalabalığın yanına düştü. izleyiciler ise yukarıdan gördüğü çölü yakından görme fırsatı yakaladı.
Vahşi Yaşam:
- 2007’de A.B.D.’nin Louisiana eyaletinde dolanan pembe yunus Erik Rue’nun objektiflerine takılmıştı. Yaklaşık 10 yıl sonra, Erik Rue, Pinky isimli bu yunusu sağlıklı ve dinç bir şekilde yeniden gördü. Herkes bu yunusun albino olduğunu düşünürken artık genetik bir sorundan ötürü deri pigmentlerinin farklılaştığı konusunda hemfikir.
https://www.youtube.com/watch?v=FRxNWsJhkbg
- ABD’nin Denver eyaletinde bulunan Waterton Konyonu, sürekli olarak ayılarla selfie çekip doğal hayatı baltalayan ziyaretçiler sebebiyle geçici olarak kapılarını kapattı.
- Kuzeydoğu Çin’de bulunan bir hayvanat bahçesinde ise yumurtlama döneminde olan penguenler arasında ilginç bir olay yaşandı. Eşcinsel bir çift penguen, başka bir babanın yumurtasını çalarak bir nevi evlat edinerek baba oldu.
Pazarlama:
- Burberry, Apple ile anlaşarak Music sevisinin ilk sponsorlu müzik kanalını oluşturdu. Burberry’nin hazırladığı defile ile eş zamanlı olarak yanınlanan kanal, İngiliz müzik sahnesi üzerine kurulu.
- Marka bu hafta içerisinde yeni koleksiyonunun tanıtımı için Snapchat’i de kullandığı mecralar arasında kattı. Koleksiyona uyumlu Story’ler yayınlayıp Snapchat’in kullanım diline hakim bir kampanya yürüttü.
- Doritos, LGBT topluluğunu desteklemek amacıyla It Gets Better Project ile iş birliği içinde gökkuşağı renklerinde cipsler hazırladı. LGBT bayrağından yola çıkılarak hazırlanan cipsler sınırlı sayıda üretildi ve beklenenin üzerinde ilgi görerek tüm stoklar tükendi. Doritos ise bu ilgi üzerine LGBT dostu cipslerden yeniden üretmeye karar verdi.
Görsel; Doritos
- Danimarkalı yaratıcı dijital ajans INET-DESIGN markaların logo ve renkten ziyade görsel kimlik kazanma sürecini inceleyen bir video hazırladı. Çalışma, Ünlü markaların sadece logo ve font yardımıyla dahi insanların aklında yer edebileceği ve bu konumlandırmanın nasıl mümkün olduğunu kendi yöntemleriyle açıklıyor.
- Sanctuary Spa’nın hazırladığı yeni reklam filminde, sorumlulukları ve sınırları olan modern kadına, üst nesilden kadınların tavsiyelerine yer veriliyor. Tekrar genç olunamayacağını hatırlatan film, kadınların telaş ve stres içinde yaşamaktan bir nebze uzaklaşmaları gerektiğini iletiyor.
- Selahattin Birgül, şirinlikleriyle dünyanın sevgilisi olan Minyonları Yeşilçam’ın unutulmaz karakterleriyle buluşturdu. Tasarım ve adaptasyonun çekiciliği de iki kültür arasında bir köprü niteliğinde.
Görsel; Selahattin Birgül
Editörler: Mert Serim
Katkıda bulunan: İpek Altun,Yalçın Pembecioğlu
Manşet Görseli; Tokyo Flash
![Bigumigu Pazar Gazetesi [20 Eylül]](https://bigumigu.com/wp-content/uploads/2015/09/def48770247ac99d8c95369b55a429886a36d2b744878941cfbd021cf6f5285d_n.jpg)